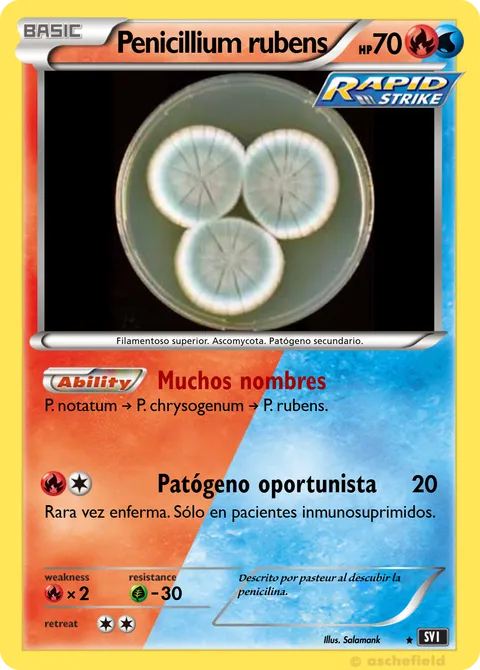

Penicillium rubens
70 HPX & Y / Black & White•Pokémon•Fire•Basic
Part of the set: Hongos
Ability: Muchos nombres
P. notatum → P. chrysogenum → P. rubens.Patógeno oportunista • 20
Weakness:
×2
Resistance:
-30
Retreat cost: 

Created by @marti0000 on 13 June 2025